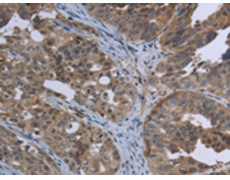
一抗

|
Background: |
Ephrin receptors, the largest subfamily of receptor tyrosine kinases (RTKs), and their ephrin ligands are important mediators of cell-cell communication regulating cell attachment, shape, and mobility in neuronal and epithelial cells |
|
Applications: |
ELISA, IHC |
|
Name of antibody: |
EPHA10 |
|
Immunogen: |
Fusion protein of human EPHA10 |
|
Full name: |
EPH receptor A10 |
|
SwissProt: |
Q5JZY3 |
|
ELISA Recommended dilution: |
1000-2000 |
|
IHC positive control: |
Human ovarian cancer |
|
IHC Recommend dilution: |
25-100 |

 購物車
購物車 幫助
幫助
 021-54845833/15800441009
021-54845833/15800441009